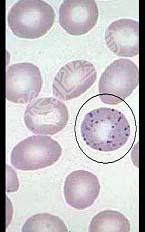

试题详情
- 多项选择题如图所示的异常红细胞可见于哪些疾病 ( )
A、再障
B、巨幼细胞贫血
C、骨髓纤维化
D、铅中毒
E、缺铁性贫血
关注下方微信公众号,搜题查看答案

热门试题
- 下列哪项不符合正常血细胞的PAS反应A、
- 对于3P试验的叙述,以下正确的是(
- 多发性骨髓瘤骨骼受累的临床表现有A、骨硬
- 急性早幼粒细胞白血病(APL)特有的遗传
- 1、根据以上临床资料,最可能诊断的疾病是
- 下列描述哪些组合是正确 ( )A、失血
- 以下关于原位溶血或无效造血的说法正确的是
- 1、患者最可能诊断是A、急性白血病B、多
- 临床上G-6-PD缺陷症分为A、蚕豆病B
- 1、造血干细胞疾病包括下列哪些疾病(
- 下述各项,有助于鉴别急性粒细胞白血病和急
- 中性粒细胞碱性磷酸酶阳性率和积分增高可见
- 1、该患者的诊断考虑的疾病有2、为进行诊
- 下列哪些疾病表现出PAdT增高A、血管性
- 可被纤溶酶水解的凝血因子有( )。A
- ITP的诊断标准包括A、多次实验室检查血
- 正常成人红细胞中Hb不包括 (
- 自然杀伤细胞活性升高常见于( )。A
- 下列FAB分型中,正确的是( )。A
- 关于巨幼细胞贫血的相关实验室检查,以下哪